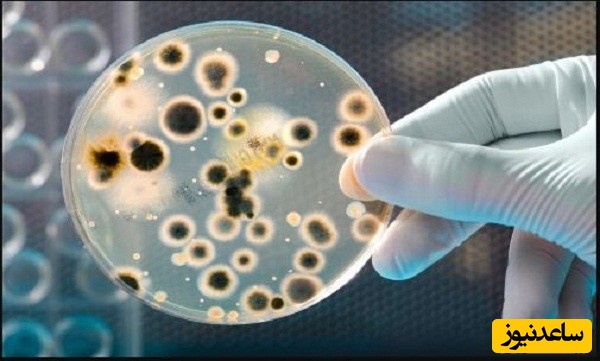
منابع دروس آزمون رشته زیست فناوری میکروبی و ضرایب آن در مقطع دکتری

به گزارش سرویس دانشگاه پایگاه خبری ساعدنیوز، با توجه به دفترچه ثبت نام آزمون دکتری 97، تمامی داوطلبانی که از تمامی رشته ها در مقطع کارشناسی ارشد فارغ التحصیل شدند، می توانند در این کدرشته امتحانی شرکت کنند. عناوین دروس امتحانی این رشته شامل موارد زیر است:
عناوین دروس امتحانی رشته زیست فناوری میکروبی در آزمون دکتری سراسری و دانشگاه آزاد | ||
سوالات دروس عمومی | سوالات دروس تخصصی در سطح کارشناسی | سوالات دروس تخصصی در سطح کارشناسی ارشد |
استعداد تحصیلی - زبان انگلیسی | بیوشیمی - بیوفیزیک - میکروبیولوژی - ژنتیک - زیست شناسی سلولی و مولکولی | بیوتکنولوژی فراورده های تخمیر - مهندسی پروتئین - ژنتیک یوکاریوت ها و ژنتیک پروکاریوت ها - بیوانفورماتیک |
ما در این قسمت تلاش کرده ایم به معرفی کتاب های موجود در بازار که می توانند به عنوان منابع مناسبی برای آمادگی آزمون دکتری 97 باشند، بپردازیم.
منابع آزمون دکتری زیست فناوری میکروبی (مطابق با آخرین تغییرات آزمون سال 97) |
زبان انگلیسی: 1ـ زبان انگلیسی عمومی دکتری 2- 1100 لغت ضروری |
استعداد تحصیلی: 1- استعداد تحصیلی (ویژه تمام گروه ها به جز فنی و مهندسی) 2- استعداد تحصیلی ، نویسندگان : هادی مسیح خواه و محمد وکیلی انتشارات فرهنگ |
مجموعه دروس در سطح کارشناسی: 1- بیوشیمی عمومی (جلد 1 و 2) تالیف دکتر پرویز شهبازی، دکتر ناصر ملک نیا 2- مبانی بیوشیمی لنین جر، ترجمه دکتر رضا محمدی بیوفیزیک: 1- بیوفیزیک برای زندگی فرید سمسارها میکروبیولوژی: 1- میکروبیولوژی عمومی، دکتر فریدون ملک زاده 2- بیوتکنولوژی میکروبی، دکتر فریدون ملک زاده 3- میکروبیولوژی جاوتز 4- میکروبیولوژی واکر 5- میکروب شناسی پزشکی، دکتر پرویز ادیب فر 6- ایمونولوژی ایوان رویت 7- ایمونولوژی استیتنر 8- ویروس شناسی فیلدز 9- ویروس شناسی فنز 10- تک یاخته شناسی، دکتر محمدی 11- میکروبیولوژی محیطی، آب، پساب و خاک، دکتر اشرف السادات نوحی 12- میکروبیولوژی، آقای دکتر آموزگار ژنتیک: 1- مبانی ژنتیک تألیف، دکتر محمد تقی آساد 23- مبانی و مسائل ژنتیک ویلیام استانس فیلد، مترجم رضا محمدی زیست شناسی سلولی و مولکولی: 1- زیست شناسی سلولی مولکولی لودیش، مترجم دکتر رضا یوسفی 2- مبانی زیست شناسی سلولی مولکولی، دورو برتیس و دورو برتیس، ترجمه، سید علی حسینی تهرانی و محمود عرفانیان احمد پور |
مجموعه دروس در سطح کارشناسی ارشد: 1- بیوتکنولوژی میکروبیولوژی صنعتی، تالیف ولف کروگر، آنالیز کروگر، ترجمه مهدی کریمی، علی مرتضوی و رسول کدخدایی، انتشارات دانشگاه فردوسی (مشهد). مهندسی پروتئین: 1- مهندسی پروتئین، تالیف سمیه صادقی و فاطمه یزدیان، انتشارات قدیس. ژنتیک یوکاریوت ها و ژنتیک پروکاریوت ها: 1ـ جاوتز، ارنست (1391)، میکروبیولوژی پزشکی، ترجمه محمدکریم رحیمی و عمید اطهری، تهران: انتشارات آییژ 2ـ ملک زاده، فریدون (1392)، میکروبیولوژی عمومی، تهران: انتشارات دانشگاه تهران 3ـ زینسر، هانس (1387)، میکروبشناسی، ترجمه محمدکریم رحیمی، تهران: انتشارات آییژ 4ـ کروگر، ولف (1388)، بیوتکنولوژی و میکروبیولوژی صنعتی، ترجمه سیدعلی مرتضوی، مشهد: انتشارات دانشگاه فردوسی مشهد 5ـ واکر، استوارت (1387)، میکروبشناسی، ترجمه رضا میرنژاد، تهران: انتشارات پیوند مهر 6- Glick, B.R., J.J. Pasternak, and C.L. Patten, Molecular Biotechnology: Principles and Applications of Recombinant DNA. 2010: ASM Press. 7.Berg, J.M., J.L. Tymoczko, and L. Stryer, Biochemistry. 2010: W. H. Freeman 8.Devlin, T.M., Textbook of Biochemistry with Clinical Correlations. 2011: Wiley. 9.Murray, R.K., et al., Harpers Illustrated Biochemistry 29th Edition. 2012: McGraw-Hill Education 10. Nelson, D.D.L., A.L. Lehninger, and M.M. Cox, Lehninger Principles of Biochemistry. 2013: W.H. Freeman. 11. Zinsser, H. and W.K. Joklik, Zinsser Microbiology. 1992: McGraw-Hill Professional Publishing. 12. Brooks, G., et al., Jawetz Melnick&Adelbergs Medical Microbiology 26/E. 2012: McGraw-Hill Education 13.Black JG (2004) Microbiology: Principles and Explorations, 6th edn. John Wiley & Sons, Chichester. 14.Dale JW and Park SF (2004) Molecular Genetics of Bacteria, 4th edn. John Wiley & Sons, Chichester. 15.Madigan MT, Martinko JM and Parker J (2003) Brock Biology of Microorganisms, 10th edn. Prentice Hall Inc., Englewood Cliffs, NJ. 16.Moat AG, Foster JW and Spector MP (2002) Microbial Physiology, 4th edn. John Wiley & Sons, Chichester. 17.Prescott LM, Harley JP and Klein DA (2004) Microbiology, 6th edn. McGraw-Hill, New York. 18.Bhamrah HS and Juneja K (2002) An Introduction to the Protozoa, 2nd edn. Anmol Publications, New Delhi. 19-. Murray PR, Rosenthal KS, Pfaller MA (2005) Medical Microbiology. 5th edn. Elsevier MOSBY 20. Washington C. Winn Jr. [et al].(2006) Koneman's color atlas and textbook of diagnostic microbiology. 6th edn. LIpPINCOTT WilLIAMS & WilKINS 21. Atlas RM and Bartha R (1998) Microbial Ecology: Fundamentals and Applications, 4th edn. Benjamin Cummings, San Francisco, CA. 22. Bitton G (1999) Wastewater Microbiology, 2nd edn. John Wiley & Sons, Chichester. 23.Mitchell R (etc) (1993) Environmental Microbiology. John Wiley & Sons, Chichester 24. Demain AL (2000) Microbial Technology. Trends in Biotechnology 18, 26–31. 25. Singleton P (2004) Bacteria in Biology, Biotechnology and Medicine, 6th edn. John Wiley & Sons, Chichester. 26. Waites MJ, Morgan NL, Rockey JS, Higton G (2001) Industrial Microbiology: An Introduction, Blackwell Science, Oxford 27.Adams MR and Moss MO (2000) Food Microbiology, 2nd edn. Royal Society of Chemistry, London. 28.Garbutt, J (1997) Essentials of Food Microbiology. Hodder Arnold, London. بیوانفورماتیک: 1- بیوانفورماتیک، تالیف محمدعلی ملبوبی، محمدرضا نقوی و سجاد رشیدی منفرد، انتشارات دانشگاه تهران. |
عناوین دروس امتحانی | استعداد تحصیلی و زبان انگلیسی | مجموعه دروس تخصصی در سطح کارشناسی | مجموعه دروس تخصصی در سطح کارشناسی ارشد |
ضرایب امتحانی | 1 | 4 | 4 |